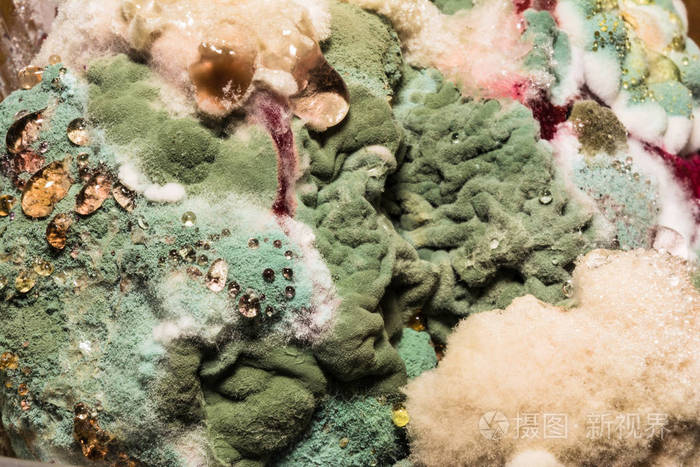
被宠坏的食物上有色霉菌的密集形成, 抽象特写背景

霉菌颜色

咖啡粉两种颜色的霉菌
图片尺寸1080x1439
显微镜下的霉菌
图片尺寸750x571
霉菌其他生物学相关
图片尺寸800x600
在腐烂的食物表面的不同颜色的霉菌
图片尺寸800x533
黄曲霉菌最好的克星?(杀灭黄曲霉菌有效方法)
图片尺寸1273x800
生产车间霉菌污染如何解决
图片尺寸690x459
墙上不同颜色的霉菌(我见到过常规灰黑色,嫩黄色和橘黄色)分别是如何
图片尺寸2448x3264
姐妹们这种白色的是霉菌吗有图谢谢
图片尺寸1080x810
aspergillus flavus
图片尺寸500x375
什么是霉菌
图片尺寸700x350
绿色黄色圆形霉菌在异质黑色表面, 宏观抽象背景
图片尺寸700x700
相亲吃饭却端来发霉的水果气的我扭头想走切开后傻眼了
图片尺寸433x419
近距离观察植物中白色发霉,菌类,果实上滋生霉菌,腐烂产品和生命.
图片尺寸1200x800
墙上不同颜色的霉菌(我见到过常规灰黑色,嫩黄色和橘黄色)分别是如何
图片尺寸2448x3264
1毫克就能致癌20毫克就能致命发霉食物中的黄曲霉素
图片尺寸1000x610
霉菌是什么预防霉菌污染食品的措施
图片尺寸800x320
霉菌分类之菌落观察——超清的菌落照片(答案在p7)
图片尺寸950x605
水面,春天,真菌,黄色,霉菌
图片尺寸1200x801
发霉图片
图片尺寸493x300
被宠坏的食物上有色霉菌的密集形成, 抽象特写背景
图片尺寸700x467